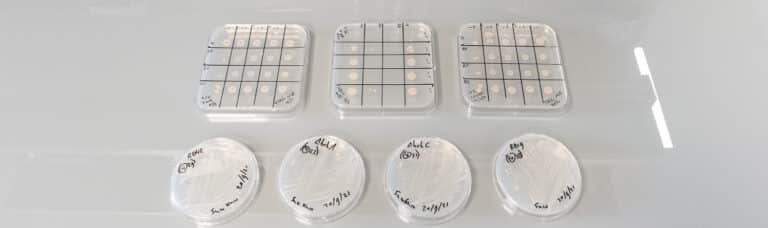

Vous êtes ici : Accueil Cité des Énergies > ACCUEIL BIAM > Actualités du BIAM
Actualités du BIAM
Actualités

Évolution du vivant
Découverte d’une « boussole vivante » qui bouscule les frontières du monde microbien Une bactérie magnétotactique

Quand l’oxygène prime sur le sucre : une autre histoire de la photosymbiose
Une équipe du BIAM, en collaboration avec le Laboratoire de Chimie Bactérienne (LCB), propose un nouveau

Interview – Lauréate du Prix Jeunes Chercheuses
Explorer le potentiel des bactéries magnétotactiques pour la médecine de demain Lauréate du Prix Jeunes Chercheuses
IrrE, l’enzyme de survie des bactéries radiotolérantes Deinococcus,
entre dans le panthéon des peptidases
Après vingt ans de recherches sur les bactéries Deinococcus, réputées pour leur résistance exceptionnelle aux radiations

MTBiocare – Grand Prix i PhD
Quand la biotechnologie réinvente le diagnostic et le traitement du cancer Chaque année, le Grand Prix

Éveiller les jeunes aux sciences et aux enjeux environnementaux :
Cordée de la Réussite du BIAM Donner vie aux découvertes scientifiques du BIAM dans les écoles

Des bactéries alliées de la reforestation face à la sécheresse
Face à l’augmentation et à l’intensification des épisodes de sécheresse menaçant les jeunes arbres, le BIAM

De la lumière bleue au carburant vert : ces bactéries qui fabriquent de l’heptane
Communiqué de presse Des chercheurs de l’Institut de Biosciences et biotechnologies d’Aix-Marseille, ont réussi à produire